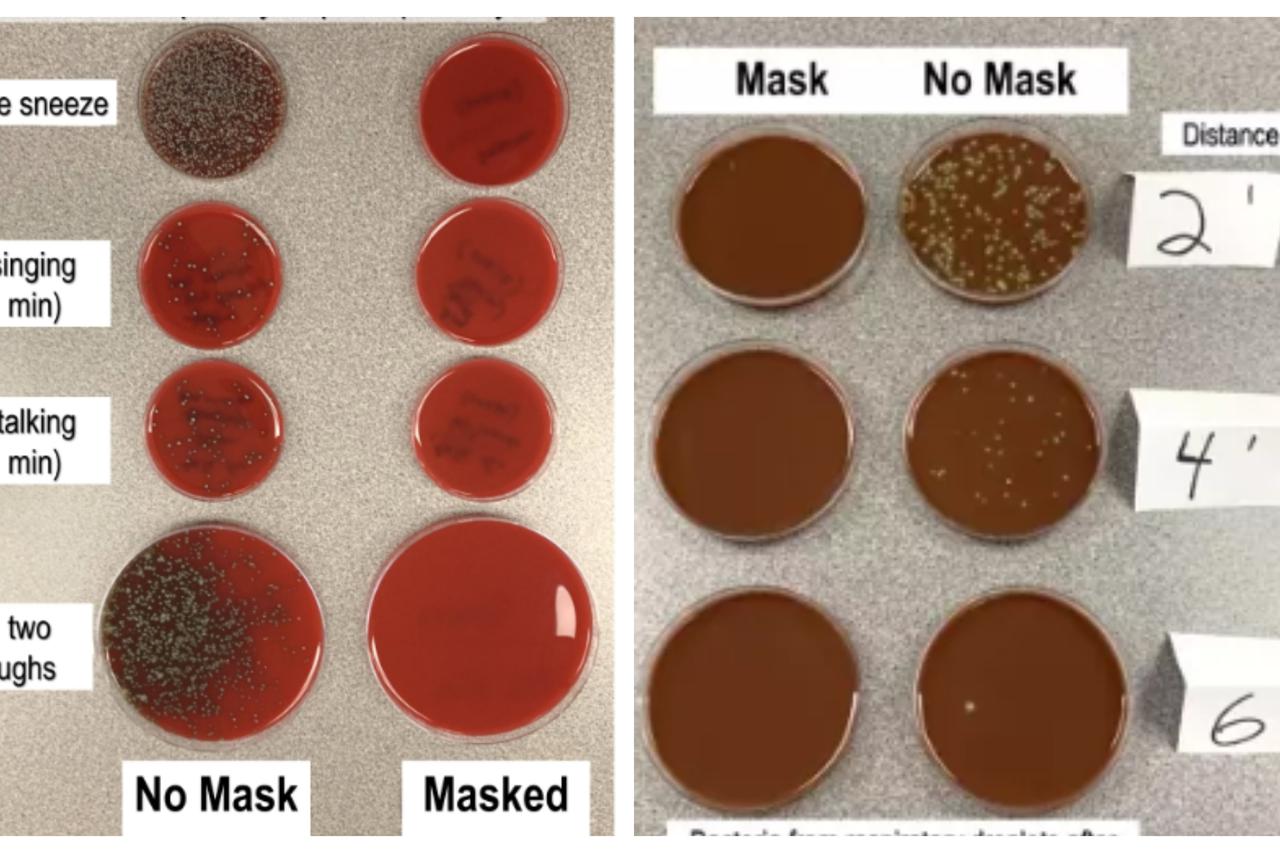

Prije desetak dana u 6 sati ujutro u autobus 217 kod Kvaternikova trga u Zagrebu ušao je putnik bez maske. Vozač ga je upozorio, putnik je negodovao, autobus nije smio krenuti, bila je pozvana policija, ali je putnik pobjegao prije nego je došla. Nakon toga je u jednom lokalnom zagrebačkom vlaku uočena putnica bez maske, a na upozorenje uzvratila je: ‘Pa nije fašnik da je nosim’. Onda je neki dan na Glavnom kolodvoru u Zagrebu, u vlak koji prometuje između Dugog Sela i Harmice, ušao putnik bez maske, vodio je dijete sa sobom. Pola sata su ga nagovarali, vlak je stajao, a tada su ga tri policajca profesionalno zgrabila, srušila na pod i stavila mu lisice, dok mu je dijete vrištalo.
Nismo samo mi sve suroviji prema ljudima bez maske. Prošli mjesec izbilo je u Južnoj Koreji 840 tučnjava zbog toga što putnici u javnom prijevozu nisu htjeli navući masku, a 43 prekršitelja završilo je na sudu. Podignimo s dna društvene piramide pogled na vrh. Ne postoji nijedna fotografija s maskom Johnsona i Putina, a navodno postoji jedna Trumpova. Trump nošenje maske shvaća kao veoma važan dio svojeg identiteta jer je nedavno za Wall Street Journal izjavio da „neki ljudi nose maske samo zato da pokažu da se s njim ne slažu“, a za Fox da nipošto neće nositi masku kad se susreće sa stranim državnicima. Usput je priznao da je masku već nosio, uz svoju tipičnu narcističku opasku: „Čak mi se pomalo sviđalo kako sam izgledao“ – kao i svako razmaženo dijete, ne čini nešto zbog drugih, nego samo zbog sebe.
Znatnu dozu narcisoidnosti pokazao je i brazilski predsjednik Jair Bolsonaro koji nije htio nositi masku dok mu to nije naredio sud, a potom je nabavio masku na kojoj je nacrtano – njegovo vlastito lice. Srećom, većina nacija ima razumnije čelnike. S maskama su se dali slikati predsjednici Slovačke Zuzana Čaputová, Kine Xi Jinping, Argentine Alberto Fernandez, Južne Koreje Moon Jea-in, Nepala Bidhya Devi Bhandari, Venezuele Nicolás Maduro, Francuske Emmanuel Macron, premijeri Italije Giuseppe Conte, Japana Shinzo Abe, Belgije Sophie Wilmès, Austrije Sebastian Kurz, Srbije Ana Brnabić, Izraela Benjamin Netanyahu. Među njima nije i njemačka kancelarka Angela Merkel, koja također još nije viđena javno s maskom, a barem se za nju ne može reći da se brine za izgled i odijevanje.
Dan nakon što je policija iznijela onog čovjeka bez maske iz vlaka, na Glavnom kolodvoru održan je prosvjedni skup njegovih istomišljenika, koji se ne protive samo nošenju maski nego i cijepljenju. Uvijek je zgodno čitati transparente koje nose mahniti jer oni na njih napišu svoju dijagnozu, a jedan krupniji muškarac nosio je ovaj natpis: “Maske opasno smanjuju dotok kisika”. Kao i kod svih luđaka, na djelu je izvrnuta logika: ako je kisik život, onda nije bezazleno da vam netko stavi na nos nešto što vam “smanjuje dotok kisika”; a ako se taj dotok smanjuje “opasno”, onda bi samo luđak stavio masku na nos. Riječ je zapravo o dobroj staroj klaustrofobiji, paničnom strahu od gušenja kada se nađete u malom zatvorenom prostoru, poput javnog prometala, ili kad vam netko stavi nešto na lice, poput maske.
Klaustrofobija je znak anksioznosti, što nije nikakva sramota, ali kada bismo si to priznali, morali bismo se pitati što je duboki izvor našeg straha, zbog čega ne možemo slobodno živjeti i kako se toga osloboditi – a za to bismo trebali pročačkati po najdubljim predjelima svoje duše, što je uvijek opasno, jer tko zna kakve se neugodne istine tamo skrivaju. Zato je lakše njegovati svoju klaustrofobiju i protiviti se maskama, i njegovati svoju paranoju i protiviti se cijepljenju, izvozeći svoje duševne probleme ostatku svijeta. Kada ćaknuti postavljaju kriterije normalnosti, onda su zapravo ćaknuti oni koji nose maske – bilo da zaštite sebe, bilo da zaštite druge.
Ne znam jeste li primijetili, ali maske uglavnom nose žene. Da biste nosili nešto tako neugodno kao što je kirurška maska, pa još po ovoj vrućini, morate biti brižni i empatični, a to su ipak češće žene nego muškarci. S tim u vezi neće vas začuditi da su buntovnici u javnom transportu, prosvjednici za slobodu disanja, u velikoj većini iskompleksirani sredovječni muškarci. Od onih 43 korejskih prekršitelja, 42 je muškog roda, uglavnom 50-godišnjaci. Sada se i kristalno jasno otkriva zašto veliki i važni vođe velikih i važnih država paradiraju raširenih nosnica, otkrivenih da ih svi vide. Narcisi moraju pokazivati svoje lice jer bi umrli da im se drugi ne dive, samo samozatajni imaju dovoljno duševne snage da se lica odreknu.

Otvori KEKS Pay
Otvori KEKS Pay

Opsesija koronom po svim znakovima spada u kult - i to vrlo agresivan kult. Svi elementi kulta su tu: Vjera u nešto što ne vidimo, ali eto, postoji i vrlo je opasno, posvuda oko nas. A može ga se umilostivita ako se slijede točno propisani rituali i način oblačenja: Sudaranje laktovima umjesto normalnog pozdrava, maske na licu (koje i simbolično pokazuju da je sljedbenicima kulta zabranjen govor tj. svako protivljenje i da su dužni slijepo, bez otpora, prihvaćati uredbe "velikih svećenika" korone - stožeraša). Postoje i obredi - dezinficiranje ruku na ulasku u svaki prostor (sličnost sa svetom vodom koju je korona-kult ukinuo i umjesto toga stavio svoju "svetu vodu" - dezinfekcijsko sredstvo), pranje ruku i drugi. Postoji i obveza poslušnosti, a postoji na žalost i nesnošljivost, i to vrlo agresivna, prema svim "ateistima" (tj. akoronašima). I mnogi su drugi elementi koji jasno pokazuju da je riječ o kultu. Ovaj novinar, na žalost, njegov je sljedbenik. Pitanje je samo je li slijepi ili je plaćeni korona-fanatik koji je zadužen za širenje kulta.